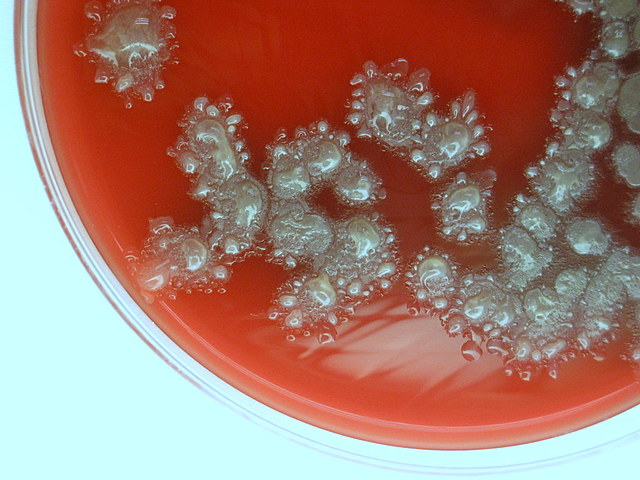
NOVO

-
Las enzimas se han visto involucradas en la elaboración de queso, conservación de alimentos y bebidas.
Homer´s Iliad menciona el uso de enzimas del estómago de niños para la elaboración de quesos. -
El famoso padre católico italiano Lazzaro Spallanzani, menciona la importancia de esta biomolécula en su trabajo de biogénesis.
-
Gottlieb Sigismud Kirchoff investigaba el proceso de convertir almidón en glucosa, señaló que se pueden usar estas biomoléculas como atalizadores
-
El Químico francés Anselme Payen, descubrió la primera enzima, diastasa.
-
La hidrólisis del almidón por la diastasa fue reconocida como una reacción de catálisis por el científico suizo Jöhns Jacob Berzelius.
-
Berzelius también interpretó que la fermentación, al ser causada por una reacción catalítica, postuló que todo cuerpo podría, por su afinidad con la sustancia fermentable, causar su unión nuevamente con los productos
-
Dubonfout demostró la actividad de la invertasa.
-
Louis Pasteur, Fedinand Cohn y Robert Koch concluyeron que la fermentación alcohólica era catalizada por las células de la levadura llamados "fermentos"
-
Wilhelm Frirdrich Kühne profesor de fisiología en la Universidad de Heidelberg, uso por primera vez el término"enzima"
-
Jokichi Takamine descubrió la takamidasa, una forma de la diastasa obtenida de Aspergillus oryzae.
-
El científico germán Otto Rohm, introduo la aplicación de enzimas pancreáticas para el golpeo de pieles en la fabricación de éstas.
-
J.M. Nelson y E.G. Griffin demostraron que enzimas inmovilizadas pueden ser retenidas a través de la absorción de la invertasa por el carbón.
-
James B. Sumner de la Universidad de Cornell, obtuvo la primera enzima en su forma pura.
-
Se utilizaron a las enzimas como herramientas para diagnóstico y proveyeron las bases para la química clínica.
Las enzimas industrialmente utilizadas son las hidrolíticas, usadas para la degradación de varias sustancias naturales.
En los detergentes predominan las proteasas. -
Sumner aisló y cristalizó la enzima ureasa de las judías.
-
John H. Northrop, Wendel M. Stanleyy Sumner ganaron el premio Nobel, por el descubrimiento del procedimiento para aislar la pepsina.
-
NOVO empezó a producir proteasas usando Bacillus lichenformis a escala comerccial.
-
Muchos sientíficos empezaron a aplicar técnicas de ingeniería genética para mejorar la producción de enzimas y sus propiedades a través de la ingeniería de las proteínas.
-
Se estima que para este año, el valor industrial de las enzimas es de 3.3 billones de dólares.
-
Se esperaba que para este año el valor industrial de las enzimas supere los 4 billoes de dólares.
Plan projects on a visual timeline
Map milestones, phases, deadlines, and key events in one place so the sequence is easier to see and share. Timetoast is a timeline maker for work, school, research, and stories.